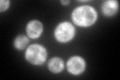
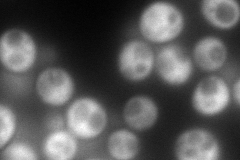
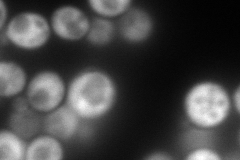
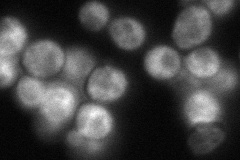
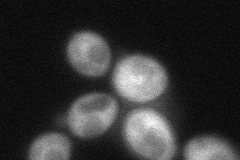
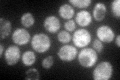

View description
eIF3 component of unknown function; deletion causes defects in mitochondrial organization but not in growth or translation initiation, can rescue cytokinesis and mitochondrial organization defects of the Dictyostelium cluA- mutant
Localization:
Intensity:
Fold change:
Significance:
-
C’ GFP library in SD
cytosol198.48 -
N' NOP1pr-GFP in SD
cytosol271.372 -
N' TEF2pr-mCherry in SD
cytosol246.821 -
N' NATIVEpr-GFP in SD
cytosol97.3268 -
N' TEF2pr-VC and Cyto-VN in SD
cytosol67.5055 -
C’ GFP library in SD+DTT

cytosol158.580.79No -
C’ GFP library in SD+H2O2

cytosol221.241.11No -
C’ GFP library in Starvation Media
cytosol121.830.61No -
C’ GFP library on the background of Pup2-DaMP

cytosol -
C’ GFP library on the background of CCT mutant

cytosol177.540.89448No
